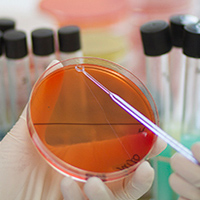
image

Кроме воды, воздуха, почвы, содержащие в тех или иных концентрациях различные микроорганизмы, в том числе и приносящие болезнь (патогенные), многие отрасли медицинской науки интересуют микробы, живущие на коже и слизистых человеческого организма, которые могут быть представлены:
- Постоянными обитателями, не несущими никакой опасности человеку, то есть, нормальной микрофлорой организма, без которой мы просто жить не можем. Например, исчезновение бактерий, живущих в кишечнике и участвующих в процессе пищеварения, приводит к дисбактериозу, лечить который – дело непростое. Так же происходит и с исчезновением вагинальной микрофлоры. Ее тут же заселяют условно-патогенные микроорганизмы, гарднереллы, например, которые вызывают бактериальный вагиноз (гарднереллез);
- Условно-патогенной флорой, которая приносит вред лишь в больших количествах при определенных условиях (иммунодефицит). Вышеназванная гарднерелла – представитель такого типа микроорганизмов;
- Наличием патогенных микробов, которые в здоровом теле не присутствуют. Они чужды человеческому организму, куда попадают случайно при контакте с другим (больным) человеком и вызывают развитие инфекционного процесса, порой, довольно тяжелого или даже смертельного. Например, встреча с возбудителями сифилиса – еще куда ни шло, на первых порах лечится, а вот (упаси Бог!) выпустит на волю холеру, чуму, черную оспу и др.
К счастью, многие из них побеждены и в настоящее время находятся «за семью печатями» в специальных лабораториях, однако человечество в любой момент должно быть готово к нашествию невидимого врага, способного уничтожить целые народы. Бактериологический посев в подобных случаях играет, пожалуй, главную роль в идентификации микроорганизма, то есть, определении рода, вида, типа и т.д. (токсономическое положение), что очень важно для диагностики инфекционных процессов, в том числе и заболеваний, передающихся половым путем.